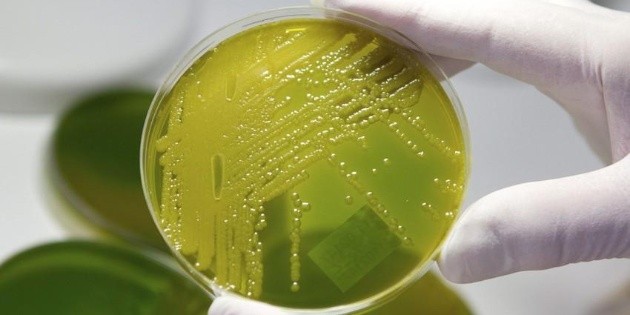
Detectan bacteria mortal en hospital de Tabasco

Cierra sus ojos
En este grupo de teatro José Ángel Rojas encontró su segunda familia, igual de amada que la sanguínea. Habló también de cómo José Ángel se integró a la actuación de su compañía. “José Ángel era un guerrero con un gran corazón, era leal, divertido, amable, inteligente, valiente y honesto. Chuy Gatica expresó: “Honestamente estoy muy consternado por la pérdida física de nuestro compañero y amigo José Ángel Rojas. “José Ángel, mejor conocido como “Rojas”.
Source: El Mañana June 08, 2019 18:33 UTC
Loading...
Loading...